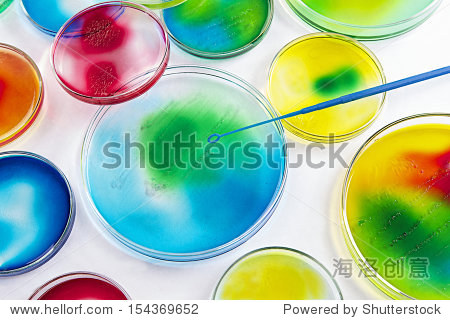
microbiology - seeding petri dishes

walking petri dishes
30 pack plastic petri dish,90x15mm clear petri dishes with l
图片尺寸640x640
10pcs/lot practical sterile petri dishes with lids for lab p
图片尺寸800x800american states are now petri dishes of polarisation
图片尺寸1080x1311
clear glass glass petri dishes cell erile culture dish lab
图片尺寸800x800
petri dishes out a punishment
图片尺寸1365x2048
10pcs sterile plastic petri dishes lab cell tissue culture d
图片尺寸1001x1001
jetting lab supplies 10pcs practical sterile petri dishes wi
图片尺寸800x800
four scientists in white lab coats with petri dishes
图片尺寸1024x683
when a few mold spores landed on some neglected petri dishesinn
图片尺寸800x533
petri dishes
图片尺寸1000x668
hda glass petri dishes for sale silica glass hp001 petri dish
图片尺寸800x533
petri dishes
图片尺寸1024x682
disposable plastic petri dishes no vents 90*15mm
图片尺寸1060x795
microbiology - seeding petri dishes
图片尺寸450x320
round petri dishes
图片尺寸640x640
sterile lab sterile 100mm plastic glass petri dishes - buy petri
图片尺寸926x1920
woman working with petri dishes in the lab
图片尺寸345x230
best quality sterile medical petry dish biological petri dishes
图片尺寸800x800
woman working with petri dishes in the lab
图片尺寸345x230
香水有记忆力吗成都宏文探究式学习十万个为什么修炼出众领域小专家
图片尺寸700x876
猜你喜欢:washthedisheswalkingstickwalkingdeadfirewalkingwalkingcartoonwalkingbasswalkingdead厂牌firewalking钢琴林彦俊firewalkingwalkingstick昆虫walkingdead厂牌手势walkingwalkingdead厂牌壁纸firewalking简谱firewalking五线谱walking是什么意思firewalking简谱双手firewalking钢琴谱dishesfirewalking简谱数字walking图片firewalking钢琴谱双手walking卡通偶练firewalking吉他谱petridishdishes怎么读firewalking钢琴谱简谱walking简笔画petri云南边境贩枪一步一步教你画嘴巴古代入座之礼图片一百以内的质数阴婷仙子田字格空白模板word石字颜体楷书无面人恐怖iq博士漫画图片黄河入海流简笔画马超张飞大战葭萌关玉所